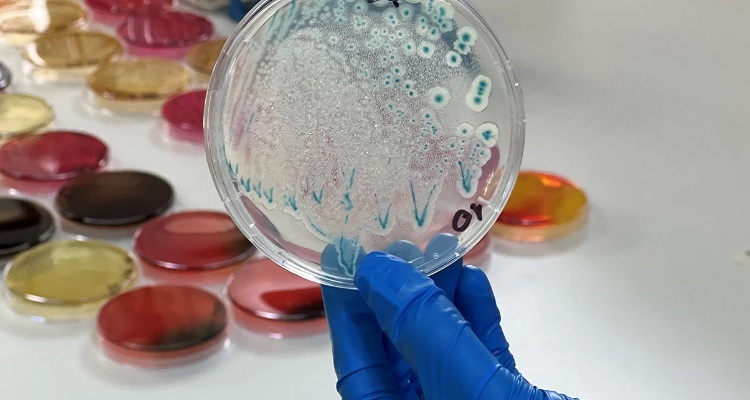

Dos investigadoras de INCAR liderarán proyectos Fondecyt enfocados en el estudio de Piscirickettsia salmonis y su impacto en salmones y truchas.
Dos Investigadoras del Centro Interdisciplinario para la Investigación Acuícola (INCAR), Dra. Yeny Leal Acosta y Dra. Raibel Suárez, se adjudicaron Proyectos Fondecyt de Postdoctorado. Conoce más detalles sobre las investigaciones que cada una liderará durante 2025.
“Desentrañando el panorama de las células inmunes en el salmón del Atlántico infectado con genogrupos de Piscirickettsia salmonis mediante secuenciación de ARN de núcleo único (snRNA-seq)”.
La Investigadora de la línea “Genómica Acuícola”, Dra. Yeny Leal Acosta, se adjudicó un Fondecyt de Postdoctorado, con el proyecto “Unraveling the immune cells landscape in Atlantic salmon infected with Piscirickettsia salmonis genogroups by single-nuclei RNA sequencing (snRNA-seq)”.

“Este proyecto tiene como objetivo investigar la heterogeneidad de las células inmunes en el riñón anterior del salmón del Atlántico infectado con diferentes genogrupos de P. salmonis y y evaluar la respuesta a la inmunización con vacunas inactivadas mediante análisis de snRNA-seq. De esta manera, proponemos comparar la respuesta transcriptómica celular en riñón anterior de salmón del Atlántico infectados con dos genogrupos de P. salmonis. Además, buscamos identificar genes marcadores celulares específicos en riñón anterior que permita diferenciar las respuestas inmunológicas asociadas a cada uno de estos genogrupos. Finalmente, estudiaremos el impacto que tiene la inmunización con bacterinas procedentes de cada genogrupo sobre los diferentes linajes celulares presentes en el riñón anterior del salmón del Atlántico”, explicó la Dra. Leal Acosta.
La investigación pretende dilucidar los mecanismos patogénicos subyacentes dentro de cada población celular huésped impactada, contribuyendo al desarrollo de estrategias más eficaces de vacunación y control de enfermedades. Como resultado, se espera generar biomarcadores moleculares celulares para identificar distintos genogrupos de P. salmonis, lo que permitirá asociar el nivel de virulencia de los genogrupos bacterianos al panorama de las poblaciones de células inmunes en el salmón del Atlántico.
La P. salmonis es uno de los patógenos más prevalentes en la salmonicultura nacional, responsable del 52,4% de las infecciones relacionadas a la mortalidad de salmónidos. Actualmente, para su control existe una estrategia de vacunación centrada en una sola cepa (EM-90); por lo que posee una eficacia limitada, ya que no proporciona protección contra todos los genogrupos y no logra estimular estimular adecuadamente el sistema inmunológico celular, algo que se espera esta investigación pueda cambiar.
“Esperamos que el conocimiento molecular generado durante esta propuesta se aplique para caracterizar la severidad del proceso de infección de P. salmonis a nivel molecular y celular”, detalló la
Investigadora Postdoctoral de INCAR.
“Estudio de los mecanismos celulares asociados a la respuesta morfo-funcional de las células epiteliales de branquia e Intestino de trucha arcoiris RTGut-GC y RTGill-W1 por la infección de Piscirickettsia salmonis”.
La Investigadora de la línea “Salud Animal en Ambiente Marino”, Dra. Raibel Suárez, se adjudicó un Fondecyt de Postdoctorado, con el proyecto “Study of cellular mechanisms associated with the morphofunctional response of rainbow trout intestinal and gill epithelial cells RTGut-GC and RTGillW1 during infection with Piscirickettsia salmonis”.
El proyecto cuenta con el patrocinio del Investigador Asociado del Centro INCAR y Académico de la Universidad Austral de Chile de Valdivia, Dr. Alex Romero Zúñiga.
El objetivo del proyecto es caracterizar in vitro el proceso infectivo de Piscirickettsia salmonis en las células epiteliales de branquia e intestino de trucha arcoíris, específicamente se evaluarán las implicaciones de la respuesta proinflamatoria y la expresión génica en la traslocación de la bacteria y en la alteración de la morfofuncionalidad del epitelio.
 “Numerosos antecedentes demuestran que P. salmonis ingresa por los tejidos epiteliales y además se conocen los mecanismos celulares implicados en la infección de los macrófagos en cultivo, pero aún no se describe el grado de participación de las células epiteliales en la infección, es decir si son también un blanco de infección o si sólo son atravesadas por la bacteria de manera paracelular sin infectarse”, puntualiza la Dra. Suárez.
“Numerosos antecedentes demuestran que P. salmonis ingresa por los tejidos epiteliales y además se conocen los mecanismos celulares implicados en la infección de los macrófagos en cultivo, pero aún no se describe el grado de participación de las células epiteliales en la infección, es decir si son también un blanco de infección o si sólo son atravesadas por la bacteria de manera paracelular sin infectarse”, puntualiza la Dra. Suárez.
Como está bien documentado, uno de los principales problemas que afecta la salmonicultura es la infección continua de P. salmonis, lo que promueve el uso constante de altas dosis de antibióticos y con ello incrementa la resistencia bacteriana y el daño al ambiente.
Esta investigación de manera indirecta espera aportar resultados que permitan reducir el uso de antibióticos en el ambiente marino, los cuales al igual que la bacteria ingresan por el epitelio y al describir el mecanismo de infección de la bacteria podremos comprender cuan efectivos son los antibióticos para contrarrestar el ingreso de la bacteria al tejido subyacente a través del epitelio y la importancia del uso de alternativas no farmacológicas para mejorar la salud epitelial e impedir el éxito de la infección.
“Con los resultados de esta investigación esperamos explicar algunos de los mecanismos celulares y moleculares empleados por P. salmonis en las fases tempranas de infección”, concluyó la Investigadora Postdoctoral de INCAR, Dra. Raibel Suárez





